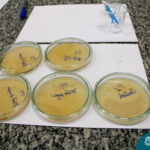

Você sabe a importância de LAVAR ÀS MÃOS?
Os estudantes do 1º ano realizaram um experimento juntamente com o professor Vagner, de Ciências, para identificar quantos microrganismos existem em nossas mãos.
Foram feitos 2 experimentos:
No primeiro, uma fatia de pão foi tocada pelos alunos com a mão suja, outra com as mãos após serem higienizadas e uma terceira utilizando luvas. Para o segundo, foram utilizadas placas de Petri com gelatina, e o mesmo procedimento foi feito, coletando os microrganismos da mão dos estudantes com um cotonete antes e após a lavagem das mãos.
O objetivo é acompanharem e compararem m os resultados de ambos os experimentos durante a semana.
Isso é Puri!